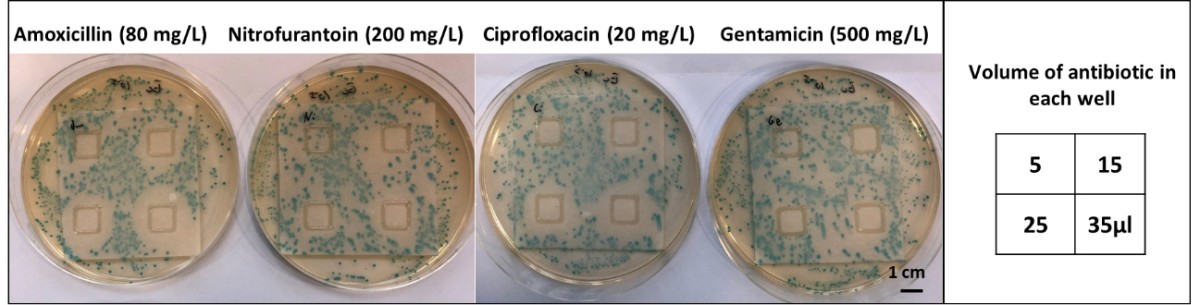
На этом фото показан полный вариант теста с четырьмя антибиотиками. Фото.

Как правило, лечение вызванных болезнетворными бактериями инфекционных заболеваний занимает довольно много времени. Сначала докторам необходимо взять у пациента анализы крови или мочи, а затем проверить, какими именно микроорганизмами вызвано заболевание. Только после этого лечащий врач может прописать антибиотики, которые должны помочь, но чаще всего людям назначаются лекарства широкого спектра действия. Они не настолько эффективны, как нацеленные на определенные бактерии средства, а также негативно влияют на способность организма противостоять бактериям в будущем. Было бы классно, если в распоряжении врачей имелся недорогой тест, который может быстро выявить наличие бактерий в анализах крови или мочи человека и показать, какой именно антибиотик ускорит лечение. А такой тест уже есть и создан сотрудниками Саутгемптонского университета (Англия).

Антибиотики широкого спектра действия неэффективны против некоторых болезней
О необычном тесте, разработанным британскими учеными, было рассказано в научном издании New Atlas. Он состоит из трех слоев, у каждого из которых есть свое предназначение. Верхний слой визуально разделен на четыре части, каждая из которых пропитана четырьмя часто используемыми видами антибиотиков. Средним слоем является впитывающая жидкости бумага. Нижний слой, в свою очередь, состоит из геля с благоприятными условиями для роста и развития бактерий. Весь тест запечатан в пластиковый футляр, который защищает его от внешних воздействий.
А вы знали, что в научной литературе и документах вместо термина «антибиотики» обычно используется словосочетание «противомикробные препараты»?
Как выбрать эффективный антибиотик?
По словам исследователей, пользоваться созданным им тестом очень просто. Анализы пациента впитываются в средний слой теста, который помещается в контейнер. Если в жидкости есть болезнетворные бактерии, под воздействием геля из нижнего слоя они начинают активно размножаться. Затем они начинают соприкасаться с верхним слоем, на который нанесены четыре разных антибиотика. Со временем материал начинает синеть, но одна из четырех частей верхнего слоя остается чистой. Это значит, что антибиотик из этой части хорошо убивает обнаруженные в анализах бактерии и для лечения пациента нужно использовать именно это средство.

На фото показан упрощенный вариант теста с одним антибиотиком, а не четырьмя. Посередине слой не окрашен в синий цвет, значит, антибиотик подходит для лечения заболевания
Также на эту тему: Создан пластырь, который распознает устойчивые к антибиотикам бактерии
Чтобы проверить эффективность теста, ученые пропитали средний слой искусственной мочой с бактериями кишечной палочки. Как они и ожидали, тест показал наиболее эффективный антибиотик против этого вида бактерий. В целом, точность разработанного метода оказалась не ниже, чем у стандартных способов подбора антибиотиков. Но преимущество нового метода состоит в том, что такие тесты стоят недорого, просты в использовании и быстрее выдают результат.
На этом фото показан полный вариант теста с четырьмя антибиотиками
Если вам интересны новости науки и технологий, подпишитесь на наш канал в Яндекс.Дзен. Там вы найдете материалы, которые не были опубликованы на сайте!
Благодаря новому медицинскому изобретению, изучение анализов пациентов может заметно ускориться. Начать лечение можно будет на несколько дней раньше, причем без употребления антибиотиков широкого спектра действия, о вреде которых упоминалось в начале статьи. К тому же, новый тест может сократить количество случаев, когда врачи по ошибке назначают пациентам антибиотики, хотя они им и не нужны. В долгосрочной перспективе это медицинское новшество может снизить скорость обретения бактерий устойчивости к антибиотикам.



Новости, статьи и анонсы публикаций
Чат с читателямиСвободное общение и обсуждение материалов